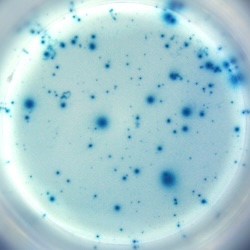

IFN-gamma specific spots produced by 1x10E4 mouse (BALB/c) splenocytes.
Stimulation: PMA/ionomycin.
Stimulation: PMA/ionomycin.
Catalogue Number
CT317-B2
Description
Mouse IFN-γ T cell ELISPOT kit - 2-plate
Price
€ 485.00
staining
Enzymatic
Characteristics
PVDF
Contents
- Coating antibody
- Biotinylated detection antibody
- Streptavidin-HRP
- TMB substrate
- Blocking stock solution
- Dilution buffer
- Tween-20
- PVDF ELISPOT plates with lids and cover slips
- Manual
References list
- STING activator 2'3'-cGAMP enhanced HSV-1-based oncolytic viral therapy.
- Oral delivery of bi-autoantigens by bacterium-like particles (BLPs) against autoimmune diabetes in NOD mice.
- Phenotype and fate of liver-resident CD8 T cells during acute and chronic hepacivirus infection.
- B21 DNA vaccine expressing ag85b, rv2029c, and rv1738 confers a robust therapeutic effect against latent infection.
- The self-peptide repertoire plays a critical role in transplant tolerance induction.
- Ex vivo IL-15 replenishment augments bone marrow precursor cell-mediated adaptive immunity via PI3K-Akt pathway.
- A novel method for efficient generation of antigen-specific effector T-cells using dendritic cells transduced with recombinant adeno-associated virus and p38 kinase blockade.
- Down selecting adjuvanted vaccine formulations: a comparative method for harmonized evaluation.
- Development of a more efficient hepatitis B virus vaccine by targeting hepatitis B virus preS to dendritic cells.
- Identification of cytotoxic T lymphocyte epitopes in dengue virus serotype 1.
- Increased antigen presentation but impaired T cells priming after upregulation of interferon-beta induced by lipopolysaccharides is mediated by upregulation of B7H1 and GITRL.
- Gene therapy for tolerance: high-level expression of donor major histocompatibility complex in the liver overcomes naive and memory alloresponses to skin grafts.
- The preparation of human papillomavirus type 58 vaccine and exploring its biological activity and immunogenicity in vitro.
- Synthetic peptides containing B- and T-cell epitope of dengue virus-2 E domain III provoked B- and T-cell responses.
- Key role of the GITR/GITRLigand pathway in the development of murine autoimmune diabetes: a potential therapeutic target.
- Vaccination of mice with recombinant baculovirus expressing spike or nucleocapsid protein of SARS-like coronavirus generates humoral and cellular immune responses.
- Chimaeric protein improved immunogenicity compared with fusion protein of Ag85B and ESAT-6 antigens of Mycobacterium tuberculosis.



